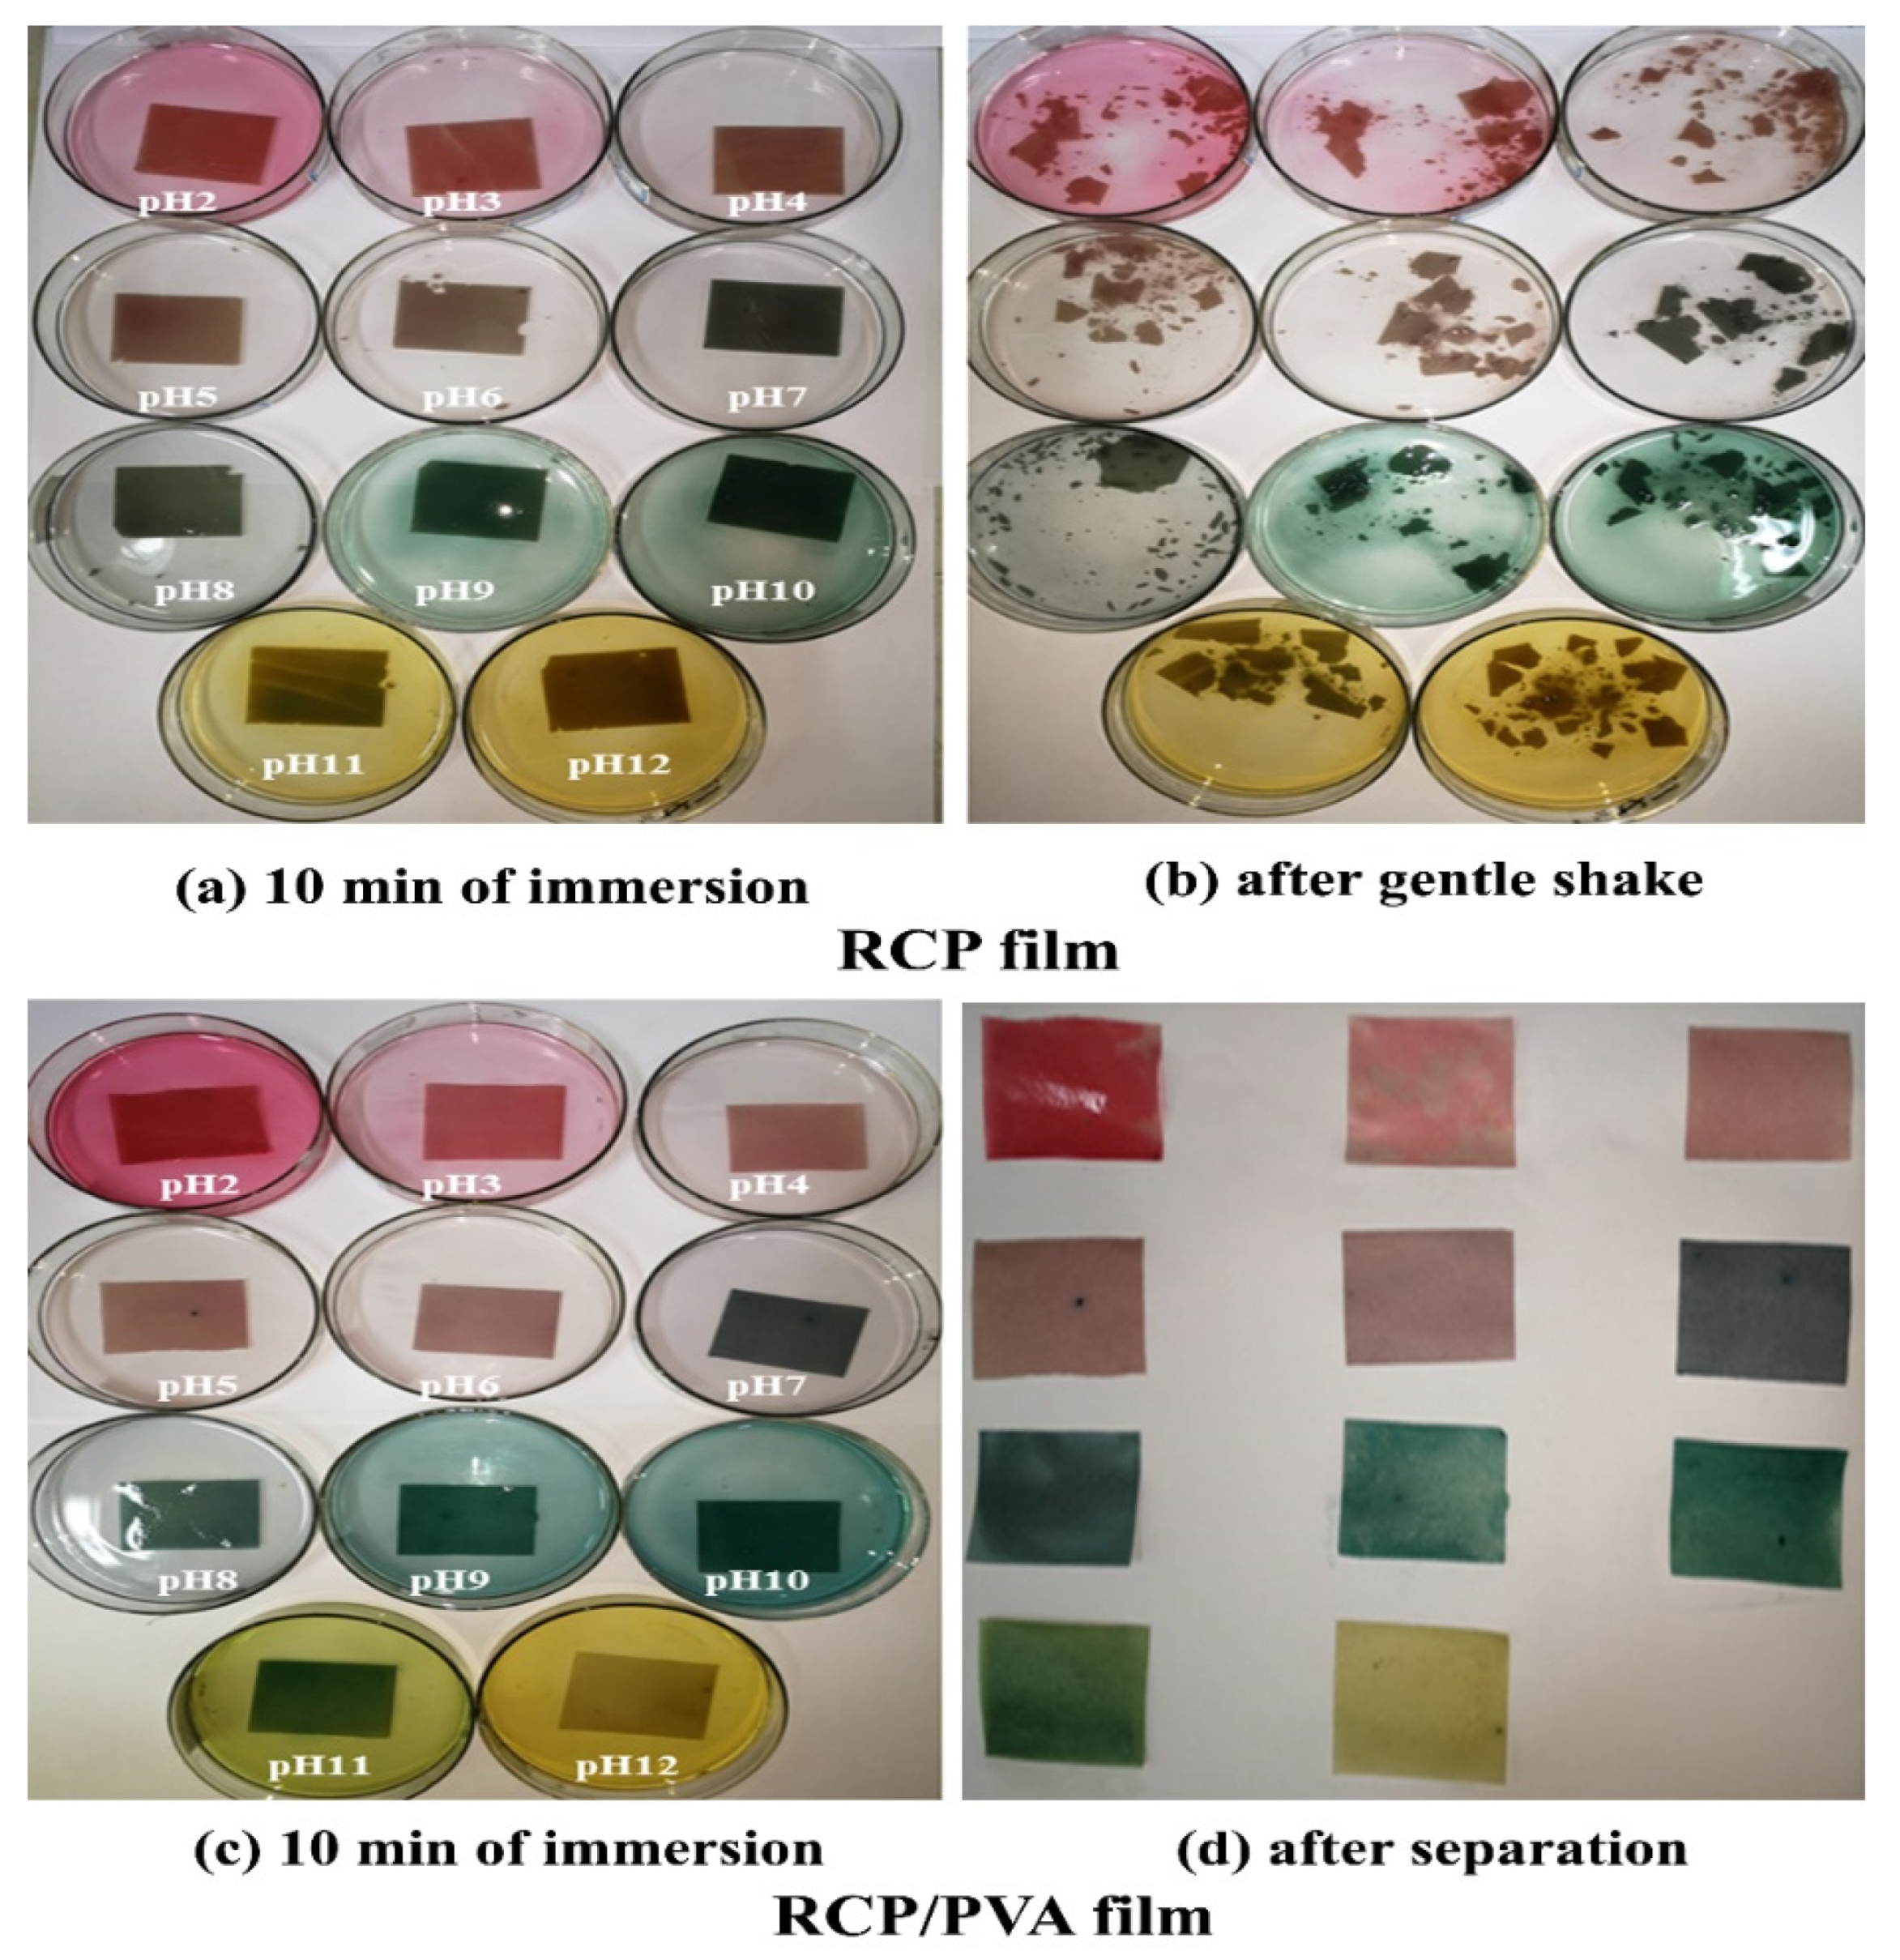
Foods 11 03371 g006 Foods 11 03371 g006

A Facile Strategy for Development of pH-Sensing Indicator Films Based on Red Cabbage Puree and Polyvinyl Alcohol for Monitoring Fish Freshness
Abstract
1. Introduction
2. Materials and Methods
2.1. Materials
2.2. Preparation of FFSs
2.3. Characterization of FFSs
2.3.1. Particle Size Distribution (PSD)
2.3.2. pH
2.3.3. Total Anthocyanin Concentration (TAC)
2.3.4. UV−Vis Spectra Measurement
2.3.5. Rheological Properties
2.4. Preparation of the Films
2.5. Characterization of the Films
2.5.1. Fourier-Transform Infrared (FTIR) Spectroscopy
2.5.2. Scanning Electron Microscope (SEM)
2.5.3. Physical Properties
2.5.4. Color Response Properties
2.6. Application in Monitoring Freshness of Fish
2.7. Statistical Analysis
3. Results and Discussion
3.1. Characterization of FFSs
3.1.1. PSD, pH, and TAC of RCP Suspension
3.1.2. Rheological Properties of FFSs
3.1.3. Color Variations and UV-Vis Spectra of RCP and RCP/PVA Suspensions
3.2. Characterization of the Films
3.2.1. FTIR Analysis
3.2.2. Morphology
3.2.3. Physical Properties
3.2.4. Colorimetric Response
3.2.5. Application in Monitoring Fish Freshness
4. Conclusions
Author Contributions
Funding
Data Availability Statement
Conflicts of Interest
References
- Han, J.W.; Ruiz-Garcia, L.; Qian, J.P.; Yang, X.T. Food packaging: A comprehensive review and future trends. Compr. Rev. Food Sci. Food Saf. 2018, 17, 860–877. [Google Scholar] [CrossRef] [PubMed]
- Kalpana, S.; Priyadarshini, S.R.; Leena, M.M.; Moses, J.A.; Anandharamakrishnan, C. Intelligent packaging: Trends and applications in food systems. Trends Food Sci. Technol. 2019, 93, 145–157. [Google Scholar] [CrossRef]
- Liu, D.; Zhao, P.; Chen, J.; Yan, Y.; Wu, Z. Recent Advances and Applications in Starch for Intelligent Active Food Packaging: A Review. Foods 2022, 11, 2879. [Google Scholar] [CrossRef] [PubMed]
- Choi, I.; Lee, J.Y.; Lacroix, M.; Han, J. Intelligent pH indicator film composed of agar/potato starch and anthocyanin extracts from purple sweet potato. Food Chem. 2017, 218, 122–128. [Google Scholar] [CrossRef] [PubMed]
- Liu, D.; Zhang, C.; Pu, Y.; Chen, S.; Liu, L.; Cui, Z.; Zhong, Y. Recent Advances in pH-Responsive Freshness Indicators Using Natural Food Colorants to Monitor Food Freshness. Foods 2022, 11, 1884. [Google Scholar] [CrossRef] [PubMed]
- Zhang, X.H.; Lu, S.S.; Chen, X. A visual pH sensing film using natural dyes from Bauhinia blakeana Dunn. Sens. Actuators B Chem. 2014, 98, 268–273. [Google Scholar] [CrossRef]
- Huang, S.; Xiong, Y.; Zou, Y.; Dong, Q.; Ding, F.; Liu, X.; Li, H. A novel colorimetric indicator based on agar incorporated with arnebia euchroma root extracts for monitoring fish freshness. Food Hydrocoll. 2019, 90, 198–205. [Google Scholar] [CrossRef]
- Moradi, M.; Tajik, H.; Almasi, H.; Forough, M.; Ezati, P. A novel pH-sensing indicator based on bacterial cellulose nanofibers and black carrot anthocyanins for monitoring fish freshness. Carbohydr. Polym. 2019, 222, 115030. [Google Scholar] [CrossRef]
- Chen, H.Z.; Zhang, M.; Bhandari, B.; Yang, C.H. Novel pH-sensitive films containing curcumin and anthocyanins to monitor fish freshness. Food Hydrocoll. 2020, 100, 105438. [Google Scholar] [CrossRef]
- Luo, X.; Wang, R.; Wang, J.; Li, Y.; Luo, H.; Chen, S.; Zeng, X.; Han, Z. Acylation of Anthocyanins and Their Applications in the Food Industry: Mechanisms and Recent Research Advances. Foods 2022, 11, 2166. [Google Scholar] [CrossRef]
- Chandrasekhar, J.; Madhusudhan, M.C.; Raghavarao, K.S.M.S. Extraction of anthocyanins from red cabbage and purification using adsorption. Food Bioprod. Process. 2012, 90, 615–623. [Google Scholar] [CrossRef]
- Yong, H.; Liu, J. Recent advances in the preparation, physical and functional properties, and applications of anthocyanins-based active and intelligent packaging films. Food Packag. Shelf Life 2020, 26, 100550. [Google Scholar] [CrossRef]
- Pourjavaher, S.; Almasi, H.; Meshkini, S.; Pirsa, S.; Parandi, E. Development of a colorimetric pH indicator based on bacterial cellulose nanofibers and red cabbage (Brassica oleraceae) extract. Carbohydr. Polym. 2017, 156, 193–201. [Google Scholar] [CrossRef] [PubMed]
- Prietto, L.; Mirapalhete, T.C.; Pinto, V.Z.; Hoffmann, J.F.; Vanier, N.L.; Lim, L.T.; Dias, A.R.G.; Zavareze, E.R. pH-sensitive films containing anthocyanins extracted from black bean seed coat and red cabbage. LWT-Food Sci. Technol. 2017, 80, 492–500. [Google Scholar] [CrossRef]
- Uranga, J.; Etxabide, A.; Guerrero, P.; de la Caba, K. Development of active fish gelatin films with anthocyanins by compression molding. Food Hydrocoll. 2018, 84, 313–320. [Google Scholar] [CrossRef]
- Musso, Y.S.; Salgado, P.R.; Mauri, A.N. Smart gelatin films prepared using red cabbage (Brassica oleracea L.) extracts as solvent. Food Hydrocoll. 2019, 89, 674–681. [Google Scholar] [CrossRef]
- Wu, C.; Li, Y.; Sun, J.; Lu, Y.; Tong, C.; Wang, L.; Yan, Z.; Pang, J. Novel konjac glucomannan films with oxidized chitin nanocrystals immobilized red cabbage anthocyanins for intelligent food packaging. Food Hydrocoll. 2020, 98, 105245. [Google Scholar] [CrossRef]
- Silva-Pereira, M.C.; Teixeira, J.A.; Pereira-Júnior, V.A.; Stefani, R. Chitosan/corn starch blend films with extract from brassica oleraceae (red cabbage) as a visual indicator of fish deterioration. LWT-Food Sci. Technol. 2015, 61, 258–262. [Google Scholar] [CrossRef]
- Liang, T.; Sun, G.; Cao, L.; Li, J.; Wang, L. A pH and NH3 sensing intelligent film based on Artemisia sphaerocephala Krasch. gum and red cabbage anthocyanins anchored by carboxymethyl cellulose sodium added as a host complex. Food Hydrocoll. 2019, 7, 858–868. [Google Scholar] [CrossRef]
- Vo, T.; Dang, T.; Chen, B. Synthesis of Intelligent pH Indicative Films from Chitosan/Poly(vinyl alcohol)/Anthocyanin Extracted from Red Cabbage. Polymers 2019, 11, 1088. [Google Scholar] [CrossRef]
- Zhang, K.; Huang, T.; Yan, H.; Hu, X.; Ren, T. Novel pH-sensitive films based on starch/polyvinyl alcohol and food anthocyanins as a visual indicator of shrimp deterioration. Int. J. Biol. Macromol. 2020, 145, 768–776. [Google Scholar] [CrossRef] [PubMed]
- Liu, D.; Cui, Z.; Shang, M.; Zhong, Y. A colorimetric film based on polyvinyl alcohol/sodium carboxymethyl cellulose incorporated with red cabbage anthocyanin for monitoring pork freshness. Food Packag. Shelf Life 2021, 28, 100641. [Google Scholar] [CrossRef]
- Ma, Q.; Liang, T.; Cao, L.; Wang, L. Intelligent poly (vinyl alcohol)-chitosan nanoparticles-mulberry extracts films capable of monitoring pH. Int. J. Biol. Macromol. 2018, 108, 576–584. [Google Scholar] [CrossRef]
- Zhai, X.; Shi, J.; Zou, X.; Wang, S.; Jiang, C.; Zhang, J.; Huang, X.; Zhang, W.; Holmes, M. Novel colorimetric films based on starch/polyvinyl alcohol incorporated with roselle anthocyanins for fish freshness monitoring. Food Hydrocoll. 2017, 69, 308–317. [Google Scholar] [CrossRef]
- Liu, B.; Xu, H.; Zhao, H.; Liu, W.; Zhao, L.; Li, Y. Preparation and characterization of intelligent starch/PVA films for simultaneous colorimetric indication and antimicrobial activity for food packaging applications. Carbohydr. Polym. 2017, 157, 842–849. [Google Scholar] [CrossRef] [PubMed]
- Koosha, M.; Hamedi, S. Intelligent Chitosan/PVA nanocomposite films containing black carrot anthocyanin and bentonite nanoclays with improved mechanical, thermal and antibacterial properties. Prog. Org. Coat. 2019, 127, 338–347. [Google Scholar] [CrossRef]
- Zeng, P.; Chen, X.; Qin, Y.R.; Zhang, Y.H.; Wang, X.P.; Wang, J.Y.; Ning, Z.X.; Ruan, Q.J.; Zhang, Y.S. Preparation and characterization of a novel colorimetric indicator film based on gelatin/polyvinyl alcohol incorporating mulberry anthocyanin extracts for monitoring fish freshness. Food Res. Int. 2019, 126, 108604. [Google Scholar] [CrossRef] [PubMed]
- Kang, S.; Wang, H.; Xia, L.; Chen, M.; Li, L.; Cheng, J.; Li, X.; Jiang, S. Colorimetric film based on polyvinyl alcohol/okra mucilage polysaccharide incorporated with rose anthocyanins for shrimp freshness monitoring. Carbohydr. Polym. 2020, 229, 115402. [Google Scholar] [CrossRef]
- Otoni, C.G.; Avena-Bustillos, R.J.; Azeredo, H.M.C.; Lorevice, M.V.; Moura, M.R.; Mattoso, L.H.C.; McHugh, T.H. Recent advances on edible films based on fruits and vegetables-A review. Compr. Rev. Food Sci. Food Saf. 2017, 16, 1151–1169. [Google Scholar] [CrossRef]
- Sun, G.; Chi, W.; Zhang, C.; Xu, S.; Li, J.; Wang, L. Developing a green film with pH-sensitivity and antioxidant activity based on k-carrageenan and hydroxypropyl methylcellulose incorporating Primus maackii juice. Food Hydrocoll. 2019, 94, 345–353. [Google Scholar] [CrossRef]
- Luchese, C.L.; Sperotto, N.; Spada, J.C.; Tessaro, I.C. Effect of blueberry agro-industrial waste addition to cornstarch-based films for the production of a pH-indicator film. Int. J. Biol. Macromol. 2017, 104, 11–18. [Google Scholar] [CrossRef] [PubMed]
- Luchese, C.L.; Abdalla, V.F.; Spada, J.C.; Tessaro, I.C. Evaluation of blueberry residue incorporated cassava starch film as pH indicator in different simulants and foodstuffs. Food Hydrocoll. 2018, 82, 209–218. [Google Scholar] [CrossRef]
- Kadzińska, J.; Janowicz, M.; Kalisz, S.; Bryś, J.; Lenart, A. An overview of fruit and vegetable edible packaging materials. Packag. Technol. Sci. 2019, 32, 483–495. [Google Scholar] [CrossRef]
- Shen, Z.; Ghasemlou, M.; Kamdem, D.P. Development and compatibility assessment of new composite film based on sugar beet pulp and polyvinyl alcohol intended for packaging applications. J. Appl. Polym. Sci. 2015, 132, 41354. [Google Scholar] [CrossRef]
- Nilnakara, S.; Chiewchan, N.; Devahastin, S. Production of antioxidant dietary fibre powder from cabbage outer leaves. Food Bioprod. Process. 2009, 87, 301–307. [Google Scholar] [CrossRef]
- Ahmadiani, N.; Sigurdson, G.T.; Robbins, R.J.; Collins, T.M.; Giusti, M.M. Solid phase fractionation techniques for segregation of red cabbage anthocyanins with different colorimetric and stability properties. Food Res. Int. 2019, 120, 688–696. [Google Scholar] [CrossRef]
- Fuleki, T.; Francis, F.J. Quantitative methods for anthocyanins extraction and determination of total anthocyanin in cranberries. J. Food Sci. 1968, 33, 78–83. [Google Scholar] [CrossRef]
- ASTM. Standard Test Method for Tensile Properties of Thin Plastic Sheeting. In ASTM D882-18, Annual Book of ASTM Standards; ASTM: Philadelphia, PA, USA, 2018. [Google Scholar]
- Wu, H.; Xiao, D.; Lu, J.; Jiao, C.; Li, S.; Lei, Y.; Liu, D.; Wang, J.; Zhang, Z.; Liu, Y.; et al. Effect of high-pressure homogenization on microstructure and properties of pomelo peel flour film-forming dispersions and their resultant films. Food Hydrocoll. 2020, 102, 105628. [Google Scholar] [CrossRef]
- ASTM. Standard Test Methods for Water Vapor Transmission of Materials. In ASTM E96/E96M–16, Annual Book of ASTM Standards; ASTM: Philadelphia, PA, USA, 2016. [Google Scholar]
- Wu, H.; Lei, Y.; Zhu, R.; Zhao, M.; Lu, J.; Xiao, D.; Jiao, C.; Zhang, Z.; Shen, G.; Li, S. Preparation and characterization of bioactive edible packaging films based on pomelo peel flours incorporating tea polyphenol. Food Hydrocoll. 2019, 90, 41–49. [Google Scholar] [CrossRef]
- Tanongkankit, Y.; Chiewchan, N.; Devahastin, S. Physicochemical property changes of cabbage outer leaves upon preparation into functional dietary fiber powder. Food Bioprod. Process. 2012, 90, 541–548. [Google Scholar] [CrossRef]
- Arapitsas, P.; Sjöberg, P.J.R.; Turner, C. Characterization of anthocyanins in red cabbage using high resolution liquid chromatography coupled with photodiode array detection and electrospray ionization-linear ion trap mass spectrometry. Food Chem. 2008, 109, 219–226. [Google Scholar] [CrossRef] [PubMed]
- Wiczkowski, W.; Szawara-Nowak, D.; Topolska, J. Red cabbage anthocyanins: Profile, isolation, identification, and antioxidant activity. Food Res. Int. 2013, 51, 303–309. [Google Scholar] [CrossRef]
- Mattoso, A.; Moreira, F.K.V.; Otoni, C.G.; Lorevice, M.V.; Martins, M.A.; Mattso, L.H.C. Hydrophobic edible films made up of tomato cutin and pectin. Carbohydr. Polym. 2017, 164, 83–91. [Google Scholar]
- Pelissari, F.M.; Andrade-Mahecha, M.M.; do Amaral Sobral, P.J.; Menegalli, F.C. Optimization of process conditions for the production of films based on the flour from plantain bananas (Musa paradisiaca). LWT-Food Sci. Technol. 2013, 52, 1–11. [Google Scholar] [CrossRef]
- Zhou, L.; He, H.; Li, M.; Song, K.; Cheng, H.N.; Wu, Q. Morphological influence of cellulose nanoparticles (CNs) from cottonseed hulls on rheological properties of polyvinyl alcohol/CN suspensions. Carbohydr. Polym. 2016, 153, 445–454. [Google Scholar] [CrossRef]
- Ma, Q.; Du, L.; Yang, Y.; Wang, L. Rheology of film-forming solutions and physical properties of tara gum film reinforced with polyvinyl alcohol (PVA). Food Hydrocoll. 2017, 63, 677–684. [Google Scholar] [CrossRef]
- Augusto, P.E.D.; Ibarz, A.; Cristianini, M. Effect of high pressure homogenization (HPH) on the rheological properties of tomato juice: Time dependent and steady-state shear. J. Food Eng. 2012, 111, 570–579. [Google Scholar] [CrossRef]
- Zhou, L.; Guan, Y.; Bi, J.; Liu, X.; Yi, J.; Chen, Q.; Wu, X.; Zhou, M. Change of the rheological properties of mango juice by high pressure homogenization. LWT-Food Sci. Technol. 2017, 82, 121–130. [Google Scholar] [CrossRef]
- Zhang, L.; Liu, Z.; Han, X.; Sun, Y.; Wang, X. Effect of ethanol content on rheology of film-forming solutions and properties of zein/chitosan film. Int. J. Biol. Macromol. 2019, 134, 807–814. [Google Scholar] [CrossRef] [PubMed]
- Rakesh, G.; Deshpande, A.P. Rheology of crosslinking poly vinyl alcohol systems during film formation and gelation. Rheol. Acta 2010, 49, 1029–1039. [Google Scholar] [CrossRef]
- Bkowska, A.; Kucharska, A.Z.; Oszmiański, J. The effects of heating, UV irradiation, and storage on stability of the anthocyanin-polyphenol copigment complex. Food Chem. 2003, 81, 349–355. [Google Scholar] [CrossRef]
- Wu, X.; Prior, R.L. Systematic identification and characterization of anthocyanins by HPLC-ESI-MS/MS in common foods in the United States: Fruits and berries. J. Agric. Food Chem. 2005, 53, 2589–2599. [Google Scholar] [CrossRef]
- Liu, S.; Fu, Y.; Nian, S. Buffering colour fluctuation of purple sweet potato anthocyanins to acidity variation by surfactants. Food Chem. 2014, 162, 16–21. [Google Scholar] [CrossRef]
- Priyadarshi, R.; Ezati, P.; Rhim, J.W. Recent advances in intelligent food packaging applications using natural food colorants. ACS Food Sci. Technol. 2021, 1, 124–138. [Google Scholar] [CrossRef]
- Jiang, G.; Hou, X.; Zeng, X.; Zhang, Z.; Wu, H.; Shen, G.; Li, S.; Luo, Q.; Li, M.; Liu, X.; et al. Preparation and characterization of indicator films from carboxymethyl-cellulose/starch and purple sweet potato (Ipomoea batatas (L.) lam) anthocyanins for monitoring fish freshness. Int. J. Biol. Macromol. 2020, 143, 359–372. [Google Scholar] [CrossRef]
- Wu, H.; Xiao, D.; Lu, J.; Li, T.; Jiao, C.; Li, S.; Lu, P.; Zhang, Z. Preparation and Properties of Biocomposite Films Based on Poly(vinyl alcohol) Incorporated with Eggshell Powder as a Biological Filler. J. Polym. Environ. 2020, 28, 2020–2028. [Google Scholar] [CrossRef]
- Andrade, R.M.S.; Ferreira, M.S.L.; Gonçalves, E.C.B.A. Development and characterization of edible films based on fruit and vegetable residues. J. Food Sci. 2016, 81, E412–E418. [Google Scholar] [CrossRef]
- Tulamandi, S.; Rangarajan, V.; Rizvi, S.S.H.; Singhal, R.S.; Chattopadhyay, S.K.; Saha, N.C. A biodegradable and edible packaging film based on papaya puree, gelatin, and defatted soy protein. Food Packag. Shelf Life 2016, 10, 60–71. [Google Scholar] [CrossRef]
- Liu, B.; Zhang, J.; Liu, L.; Hotchkiss, A.T. Preparation and properties of water and glycerol-plasticized sugar beet pulp plastics. J. Polym. Environ. 2011, 19, 559–567. [Google Scholar] [CrossRef]
- Wang, X.; Sun, X.; Liu, H.; Li, M.; Ma, Z. Barrier and mechanical properties of carrot puree films. Food Bioprod. Process. 2011, 89, 149–156. [Google Scholar] [CrossRef]
- Azeredo, H.M.C.; Morrugares-Carmona, R.; Wellner, N.; Cross, K.; Bajka, B.; Waldron, K.W. Development of pectin films with pomegranate juice and citric acid. Food Chem. 2016, 98, 101–106. [Google Scholar] [CrossRef] [PubMed]
- Zhang, X.; Zhu, J.; Liu, X. Preparation and characterization of regenerated cellulose blend films containing high amount of poly(vinyl alcohol) (PVA) in ionic liquid. Macromol. Res. 2012, 20, 703–708. [Google Scholar] [CrossRef]
- Cano, A.I.; Cháfer, M.; Chiralt, A.; González-Martínez, C. Physical and microstructural properties of biodegradable films based on pea starch and PVA. J. Food Eng. 2015, 167, 59–64. [Google Scholar] [CrossRef]
- McHugh, T.H.; Huxsoll, C.C.; Krochta, J.M. Permeability properties of fruit puree edible films. J. Food Sci. 1996, 61, 88–91. [Google Scholar] [CrossRef]
- Hamada-Sato, N.; Kazushige, U.; Kobayashi, T.; Imada, C.; Watanabe, E. Quality assurance of raw fish based on HACCP concept. Food Control 2005, 16, 301–307. [Google Scholar] [CrossRef]
- Zhang, C.; Sun, G.; Cao, L.; Wang, L. Accurately intelligent film made from sodium carboxymethyl starch/κ-carrageenan reinforced by mulberry anthocyanins as an indicator. Food Hydrocoll. 2020, 108, 106012. [Google Scholar] [CrossRef]

| Film | TS (MPa) | EAB (%) | WS (%) | WVP (g·mm/m2·h·kPa) |
|---|---|---|---|---|
| PVA | 36.3 ± 1.9 a | 265.1 ± 23.1 a | 7.5 ± 0.1 c | 0.97 ± 0.06 c |
| RCP | 6.5 ± 0.4 c | 14.4 ± 2.0 b | 43.5 ± 3.0 a | 1.60 ± 0.09 a |
| RCP/PVA | 12.4 ± 0.3 b | 20.4 ± 1.4 b | 33.0 ± 0.2 b | 1.20 ± 0.15 b |
| pH Value | Color | L* | a* | b* | ΔE |
|---|---|---|---|---|---|
| origin |  | 55.46 ± 1.08 f | 31.06 ± 0.78 b | 5.50 ± 0.29 f | — |
| pH 2 |  | 55.77 ± 0.36 f | 54.04 ± 0.46 a | 18.83 ± 0.16 c | 26.6 ± 0.81 b |
| pH 3 |  | 71.22 ± 0.58 b | 23.67 ± 2.80 c | 14.26 ± 0.63 d | 19.6 ± 2.41 d |
| pH 4 |  | 70.18 ± 0.21 b | 20.33 ± 0.13 d | 14.41 ± 0.38 d | 20.28 ± 1.24 d |
| pH 5 |  | 65.72 ± 0.93 c | 13.76 ± 0.34 e | 14.04 ± 0.19 d | 21.87 ± 1.90 d |
| pH 6 |  | 61.39 ± 0.05 d | 9.84 ± 0.07 f | 10.50 ± 0.07 e | 22.60 ± 1.00 cd |
| pH 7 |  | 51.07 ± 0.45 g | −6.43 ± 0.08 h | 3.94 ± 0.20 g | 25.09 ± 0.47 bc |
| pH 8 |  | 46.74 ± 0.18 h | −12.81 ± 0.37 i | 2.64 ± 0.12 g | 20.46 ± 0.35 d |
| pH 9 |  | 51.5 ± 0.74 g | −36.18 ± 0.60 k | 12.90 ± 0.31 d | 9.97 ± 1.32 e |
| pH 10 |  | 49.75 ± 0.61 i | −36.23 ± 0.73 k | 13.22 ± 0.10 d | 10.96 ± 1.32 e |
| pH 11 |  | 57.6 ± 0.09 e | −18.73 ± 0.59 j | 26.49 ± 2.77 b | 24.88 ± 2.07 bc |
| pH 12 |  | 73.24 ± 1.42 a | −3.81 ± 0.06 g | 39.41 ± 1.13 a | 47.02 ± 1.17 a |
Publisher’s Note: MDPI stays neutral with regard to jurisdictional claims in published maps and institutional affiliations. |
© 2022 by the authors. Licensee MDPI, Basel, Switzerland. This article is an open access article distributed under the terms and conditions of the Creative Commons Attribution (CC BY) license (https://creativecommons.org/licenses/by/4.0/).
Share and Cite
Wu, H.; Jiao, C.; Li, S.; Li, Q.; Zhang, Z.; Zhou, M.; Yuan, X. A Facile Strategy for Development of pH-Sensing Indicator Films Based on Red Cabbage Puree and Polyvinyl Alcohol for Monitoring Fish Freshness. Foods 2022, 11, 3371. https://doi.org/10.3390/foods11213371
Wu H, Jiao C, Li S, Li Q, Zhang Z, Zhou M, Yuan X. A Facile Strategy for Development of pH-Sensing Indicator Films Based on Red Cabbage Puree and Polyvinyl Alcohol for Monitoring Fish Freshness. Foods. 2022; 11(21):3371. https://doi.org/10.3390/foods11213371
Chicago/Turabian StyleWu, Hejun, Chun Jiao, Shasha Li, Qingye Li, Zhiqing Zhang, Man Zhou, and Xiangyang Yuan. 2022. "A Facile Strategy for Development of pH-Sensing Indicator Films Based on Red Cabbage Puree and Polyvinyl Alcohol for Monitoring Fish Freshness" Foods 11, no. 21: 3371. https://doi.org/10.3390/foods11213371
APA StyleWu, H., Jiao, C., Li, S., Li, Q., Zhang, Z., Zhou, M., & Yuan, X. (2022). A Facile Strategy for Development of pH-Sensing Indicator Films Based on Red Cabbage Puree and Polyvinyl Alcohol for Monitoring Fish Freshness. Foods, 11(21), 3371. https://doi.org/10.3390/foods11213371







